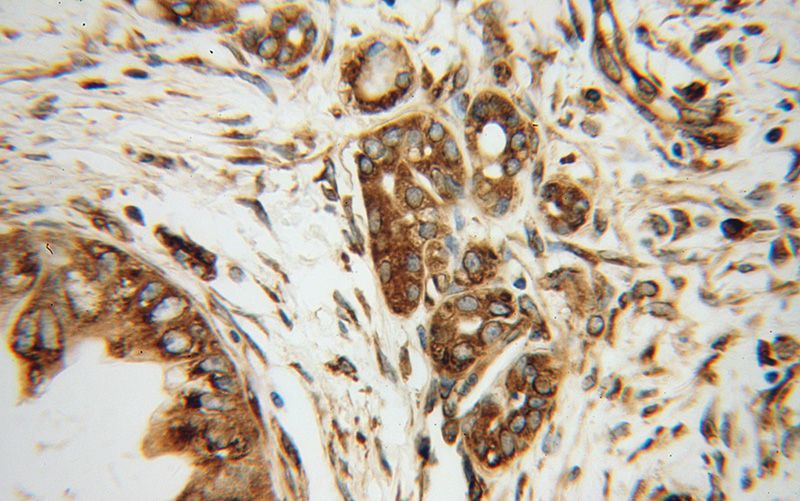
Immunohistochemical of paraffin-embedded human pancreas cancer using Catalog No:110314(EEF1D antibody) at dilution of 1:100 (under 40x lens)

-
Product Name
EEF1D antibody
- Documents
-
Description
EEF1D Rabbit Polyclonal antibody. Positive IP detected in HeLa cells. Positive IHC detected in human pancreas cancer tissue, human prostate cancer tissue. Observed molecular weight by Western-blot: 40 kDa
-
Tested applications
ELISA, IHC, IP
-
Species reactivity
Human,Mouse,Rat; other species not tested.
-
Alternative names
Antigen NY CO 4 antibody; EEF1D antibody; EF 1 delta antibody; EF 1D antibody; EF1D antibody; Elongation factor 1 delta antibody; FLJ20897 antibody; FP1047 antibody
-
Isotype
Rabbit IgG
-
Preparation
This antibody was obtained by immunization of EEF1D recombinant protein (Accession Number: XM_047421433). Purification method: Antigen affinity purified.
-
Clonality
Polyclonal
-
Formulation
PBS with 0.1% sodium azide and 50% glycerol pH 7.3.
-
Storage instructions
Store at -20℃. DO NOT ALIQUOT
-
Applications
Recommended Dilution:
IP: 1:200-1:1000
IHC: 1:20-1:200
-
Validations

Immunohistochemical of paraffin-embedded human pancreas cancer using Catalog No:110314(EEF1D antibody) at dilution of 1:100 (under 10x lens)
Immunohistochemical of paraffin-embedded human pancreas cancer using Catalog No:110314(EEF1D antibody) at dilution of 1:100 (under 40x lens)

IP Result of anti-EEF1D (IP:Catalog No:110314, 3ug; Detection:Catalog No:110314 1:300) with HeLa cells lysate 1200ug.
-
Background
EEF1D, also named as EF1D and EF 1 delta, belongs to the EF-1-beta/EF-1-delta family. It is a subunit of the elongation factor-1 complex, which is responsible for the enzymatic delivery of aminoacyl tRNAs to the ribosome. EF-1-beta and EF-1-delta stimulate the exchange of GDP bound to EF-1-alpha to GTP. EEF1D is phosphorylated upon DNA damage, probably by ATM or ATR. The calculated molecular weight of EEF1D is a 31 kDa, but the modified protein is about 40 kDa. This antibody is a rabbit polyclonal antibody raised against residues near the C terminus of human EEF1D.
-
References
- Kaitsuka T, Tomizawa K, Matsushita M. Transformation of eEF1Bδ into heat-shock response transcription factor by alternative splicing. EMBO reports. 12(7):673-81. 2011.
- Zhu Z, Xu W, Dai J. The alteration of protein profile induced by cigarette smoking via oxidative stress in mice epididymis. The international journal of biochemistry & cell biology. 45(3):571-82. 2013.
- Østergaard L, Honoré B, Thorsen LB. Pulmonary pressure reduction attenuates expression of proteins identified by lung proteomic profiling in pulmonary hypertensive rats. Proteomics. 11(23):4492-502. 2011.
Related Products / Services
Please note: All products are "FOR RESEARCH USE ONLY AND ARE NOT INTENDED FOR DIAGNOSTIC OR THERAPEUTIC USE"
